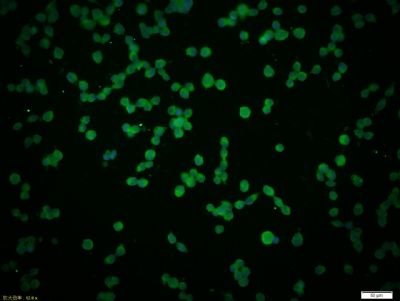
IL-4R antibody

相关产品推荐更多 >
万千商家帮你免费找货
0 人在求购买到急需产品
- 详细信息
- 技术资料
- 供应商:
上海康朗生物科技有限公司
- 库存:
大量
- 目录编号:
kl-2458R
- 克隆性:
多克隆
- 抗原来源:
Rabbit
- 保质期:
12个月
- 抗体英文名:
IL-4R antibody
- 抗体名:
白细胞介素4受体抗体
- 宿主:
Rabbit
- 适应物种:
Human, Mouse, Rat, Pig, Horse,
- 免疫原:
KLH conjugated synthetic peptide derived from human IL-4R:201-300/825 <Extracellular>
- 亚型:
IgG
- 形态:
冻干粉或液体
- 应用范围:
WB=1:500-2000 ELISA=1:500-1000 Flow-Cyt=1μg /test ICC=1:100-500
- 浓度:
1mg/ml
- 保存条件:
-20 °C
- 规格:
50ul 100ul 200ul
IL-4R antibody
| 中文名称 | 白细胞介素4受体抗体 |
| 别 名 | Interleukin-4 Receptor; 582J2.1; CD124; CD-124; CD 124; IL 4R alpha; IL4RA; Interleukin 4 receptor alpha chain; MGC118473. IL-4Rα; IL 4Rα; IL-4 Rα; IL-4-Rα; |
| 规格价格 | 50ul/780元 购买 100ul/1380元 购买 200ul/2200元 购买 大包装/询价 |
| 说 明 书 | 50ul 100ul 200ul |
| 研究领域 | 细胞生物 免疫学 细胞膜受体 细胞表面分子 |
| 抗体来源 | Rabbit |
| 克隆类型 | Polyclonal |
| 交叉反应 | Human, Mouse, Rat, Pig, Horse, |
| 产品应用 | WB=1:500-2000 ELISA=1:500-1000 Flow-Cyt=1μg /test ICC=1:100-500 (石蜡切片需做抗原修复) not yet tested in other applications. optimal dilutions/concentrations should be determined by the end user. |
| 分 子 量 | 88kDa |
| 细胞定位 | 细胞膜 分泌型蛋白 |
| 性 状 | Lyophilized or Liquid |
| 浓 度 | 1mg/ml |
| 免 疫 原 | KLH conjugated synthetic peptide derived from human IL-4R:201-300/825 <Extracellular> |
| 亚 型 | IgG |
| 纯化方法 | affinity purified by Protein A |
| 储 存 液 | 0.01M TBS(pH7.4) with 1% BSA, 0.03% Proclin300 and 50% Glycerol. |
| 保存条件 | Store at -20 °C for one year. Avoid repeated freeze/thaw cycles. The lyophilized antibody is stable at room temperature for at least one month and for greater than a year when kept at -20°C. When reconstituted in sterile pH 7.4 0.01M PBS or diluent of antibody the antibody is stable for at least two weeks at 2-4 °C. |
| PubMed | PubMed |
| 产品介绍 | background: This gene encodes the alpha chain of the interleukin-4 receptor, a type I transmembrane protein that can bind interleukin4 and interleukin 13 to regulate IgE production. The encoded protein also can bind interleukin 4 to promote differentiation of Th2 cells. A soluble form of the encoded protein can be produced by an alternate splice variant or by proteolysis of the membrane-bound protein, and this soluble form can inhibit IL4-mediated cell proliferation and IL5 upregulation by T-cells. Allelic variations in this gene have been associated with atopy, a condition that can manifest itself as allergic rhinitis, sinusitus, asthma, or eczema. Two transcript variants encoding different isoforms, a membrane-bound and a soluble form, have been found for this gene. [provided by RefSeq, Jul 2008]. Function: Receptor for both interleukin 4 and interleukin 13. Couples to the JAK1/2/3-STAT6 pathway. The IL4 response is involved in promoting Th2 differentiation. The IL4/IL13 responses are involved in regulating IgE production and, chemokine and mucus production at sites of allergic inflammmation. In certain cell types, can signal through activation of insulin receptor substrates, IRS1/IRS2. Soluble IL4R (sIL4R) inhibits IL4-mediated cell proliferation and IL5 up-regulation by T-cells. Subunit: The functional IL4 receptor is formed by initial binding of IL4 to IL4R. Subsequent recruitment to the complex of the common gamma chain, in immune cells, creates a type I receptor and, in non-immune cells, of IL13RA1 forms a type II receptor. IL4R can also interact with the IL13/IL13RA1 complex to form a similar type II receptor. Interacts with PIK3C3 (By similarity). Interacts with the SH2-containing phosphatases, PTPN6/SHIP1, PTPN11/SHIP2 and INPP5D/SHIP (By similarity). Interacts with JAK1 through a Box 1-containing region; inhibited by SOCS5. Interacts with SOCS5; inhibits IL4 signaling. Subcellular Location: Cell membrane; Single-pass type I membrane protein. Isoform 2: Secreted. Tissue Specificity: Isoform 1 and isoform 2 are highly expressed in activated T-cells. Post-translational modifications: On IL4 binding, phosphorylated on C-terminal tyrosine residues. Phosphorylation on any one of tyrosine residues, Tyr-575, Tyr-603 or Tyr-631, is required for STAT6-induced gene induction. The soluble form (sIL4R/IL4BP) can also be produced by proteolytic cleavage at the cell surface (shedding) by a metalloproteinase. Similarity: Belongs to the type I cytokine receptor family. Type 4 subfamily. Contains 1 fibronectin type-III domain. SWISS: P24394 Gene ID: 3566 Database links: Entrez Gene: 3566 Human Omim: 147781 Human SwissProt: P24394 Human Unigene: 513457 Human Important Note: This product as supplied is intended for research use only, not for use in human, therapeutic or diagnostic applications. |
| 产品图片 |  Sample: A431(Human) Cell Lysate at 30 ug U-87MG(Human) Cell Lysate at 30 ug 293T(Human) Cell Lysate at 30 ug Jurkat(Human) Cell Lysate at 30 ug Primary: Anti-IL-4R (bs-2458R) at 1/500 dilution Secondary: IRDye800CW Goat Anti-Rabbit IgG at 1/20000 dilution Predicted band size: 88 kD Observed band size: 118 kD  Sample: Testis (Mouse) Lysate at 40 ug Primary: Anti- IL-4R (bs-2458R)at 1/300 dilution Secondary: IRDye800CW Goat Anti-Rabbit IgG at 1/20000 dilution Predicted band size: 88kD Observed band size: 118kD  Tissue/cell: A431 cell; 4% Paraformaldehyde-fixed; Triton X-100 at room temperature for 20 min; Blocking buffer (normal goat serum, C-0005) at 37°C for 20 min; Antibody incubation with (IL-4R) Polyclonal Antibody, Unconjugated (bs-2458R) 1:100, 90 minutes at 37°C; followed by a conjugated Goat Anti-Rabbit IgG antibody (bs-0295G-FITC) at 37°C for 90 minutes, DAPI (5ug/ml, blue, C-0033) was used to stain the cell nuclei.  Tissue/cell: 293T cell; 4% Paraformaldehyde-fixed; Triton X-100 at room temperature for 20 min; Blocking buffer (normal goat serum, C-0005) at 37°C for 20 min; Antibody incubation with (IL-4R) Polyclonal Antibody, Unconjugated (bs-2458R) 1:100, 90 minutes at 37°C; followed by a conjugated Goat Anti-Rabbit IgG antibody (bs-0295G-FITC) at 37°C for 90 minutes, DAPI (5ug/ml, blue, C-0033) was used to stain the cell nuclei.  Blank control: Raji (blue). Primary Antibody:Rabbit Anti-IL-4R antibody(bs-2458R), Dilution: 1μg in 100 μL 1X PBS containing 0.5% BSA; Isotype Control Antibody: Rabbit IgG(orange) ,used under the same conditions ); Secondary Antibody: Goat anti-rabbit IgG-PE(white blue), Dilution: 1:200 in 1 X PBS containing 0.5% BSA. Protocol The cells were fixed with 2% paraformaldehyde (10 min). Primary antibody (bs-2458R, 1μg /1x10^6 cells) were incubated for 30 min on the ice, followed by 1 X PBS containing 0.5% BSA + 1 0% goat serum (15 min) to block non-specific protein-protein interactions. Then the Goat Anti-rabbit IgG/PE antibody was added into the blocking buffer mentioned above to react with the primary antibody at 1/200 dilution for 30 min on ice. Acquisition of 20,000 events was performed. |
风险提示:丁香通仅作为第三方平台,为商家信息发布提供平台空间。用户咨询产品时请注意保护个人信息及财产安全,合理判断,谨慎选购商品,商家和用户对交易行为负责。对于医疗器械类产品,请先查证核实企业经营资质和医疗器械产品注册证情况。
 技术资料
技术资料暂无技术资料 索取技术资料
IL-4R antibody
¥780 - 2200